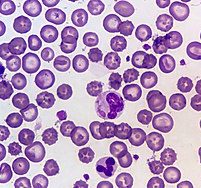

مقدمه
بیماری دیستمپر سگ ( Canine Distemper.V) یک عفونت ویروسی بسیار مسری و کشنده است که توسط ویروس دیستمپر کانین (CDV) ایجاد میشود. این ویروس از خانواده پارامیکسوویریده و جنس موربیلی ویروس است که با ویروسه ای سرخک انسان و طاعون گاوی شباهت آنتیژنیک دارد . دیستمپر پس از هاری، دومین بیماری مرگبار در سگ ها محسوب میشود و سیستمهای تنفسی، گوارشی، عصبی و پوستی را درگیر میکند . در این مقاله به بررسی جامع اپیدمیولوژی، علائم، تشخیص، درمان و پیشگیری این بیماری پرداخته میشود.
اتیولوژی و راههای انتقال
ویروس دیستمپر از طریق ترشحات تنفسی (عطسه، سرفه) و تماس مستقیم با مایعات بدن حیوان آلوده (ادرار، بزاق، مدفوع) منتقل میشود . این ویروس در محیط های سرد تا چند هفته زنده میماند، اما در دمای بالا به سرعت از بین میرود . انتقال عمودی (از مادر به جنین) نیز امکان پذیر است و ممکن است منجر به سقط جنین یا توله های با نقایص مادرزادی شود .
میزبان های مستعد:
- سگهای واکسینه نشده، به ویژه توله های ۳ تا ۶ ماهه .
- حیوانات وحشی مانند راسو، روباه، راکون و برخی گربه سانان بزرگ .
پاتوژنز و علائم بالینی
ویروس ابتدا به سلولهای سیستم ایمنی (لنفوسیتها) حمله کرده و پاسخ ایمنی را تضعیف میکند. سپس به اپیتلیوم دستگاه تنفسی، گوارشی و سیستم عصبی مرکزی گسترش مییابد . علائم در دو فاز ظاهر میشوند:
فاز اولیه (غیرعصبی):
- تب متناوب (۳۹-۴۱ درجه سانتیگراد)
- ترشحات چرکی از چشم و بینی
- سرفه، ذات الریه، بی اشتهایی
- اسهال و استفراغ .
فاز عصبی (معمولاً ۱-۳ هفته پس از علائم اولیه):
- تشنج، انقباضات عضلانی
- عدم تعادل، فلج اندامها
- هایپرکراتوز کف پا (سفتی و ضخیم شدن بالشتکها) .
- در موارد پیشرفته: نابینایی، تغییرات رفتاری و مرگ.
نکته: ۵۰٪ سگهای مبتلا به علائم عصبی زنده نمی مانند و بهبودیافتگان اغلب آسیب های عصبی دائمی دارند .
تشخیص
تشخیص بر پایه ترکیبی از تاریخچه بالینی، علائم و آزمایشهای اختصاصی است:
- کیتهای سریع ایمنوکروماتوگرافی: تشخیص آنتی ژن ویروس از ترشحات چشم/بینی .
- PCR: شناسایی RNA ویروس در خون یا مایع مغزی-نخاعی .
- تست سرولوژی: اندازه گیری آنتی بادیهای IgM و IgG (ممکن است در سگهای واکسین هشده تداخل ایجاد کند) .
- تستهای تکمیلی: کاهش لنفوسیتها در CBC، رادیوگرافی برای پنومونی.
درمان
هیچ درمان ضدویروسی اختصاصی برای دیستمپر وجود ندارد و مدیریت بیماری شامل مراقبت های حمایتی است:
- تزریق مایعات و الکترولیتها: جبران دهیدراتاسیون ناشی از اسهال و استفراغ .
- آنتیبیوتیک های گسترده اثر (مانند آموکسیسیلین): کنترل عفونتهای ثانویه باکتریایی.
- داروهای ضدتشنج (فنوباربیتال، دیازپام): مدیریت علائم عصبی .
- تغذیه با رژیم پرانرژی: تقویت سیستم ایمنی .
نکته حیاتی: سگهای مبتلا باید قرنطینه شوند تا از انتقال ویروس به سایر حیوانات جلوگیری شود .
پیشگیری
واکسیناسیون موثرترین روش پیشگیری است:
- برنامه واکسیناسیون:
- دوز اول: ۶-۸ هفتگی
- دوز دوم: ۱۰-۱۲ هفتگی
- دوز سوم: ۱۴-۱۶ هفتگی
- یادآور سالانه .
- اجتناب از تماس با حیوانات آلوده: به ویژه در توله های زیر ۴ ماه .
- ضدعفونی محیط: استفاده از محلول های حاوی کلر یا گلوتارآلدئید .
سوالات متداول
آیا دیستمپر به انسان منتقل میشود؟
خیر. این بیماری مختص پستانداران است و تاکنون گزارشی از انتقال آن به انسان ثبت نشده است .
چرا برخی سگها پس از واکسیناسیون مبتلا میشوند؟
واکسن ها مصونیت ۱۰۰٪ ایجاد نمیکنند. عوامل مانند نقص ایمنی، سویه های ویروس جهش یافته یا تداخل آنتی بادی های مادری ممکن است اثر واکسن را کاهش دهند .
آیا سگهای بهبودیافته ناقل ویروس هستند؟
بله. ویروس تا ۴ ماه پس از بهبودی از طریق ترشحات بدن دفع میشود .
